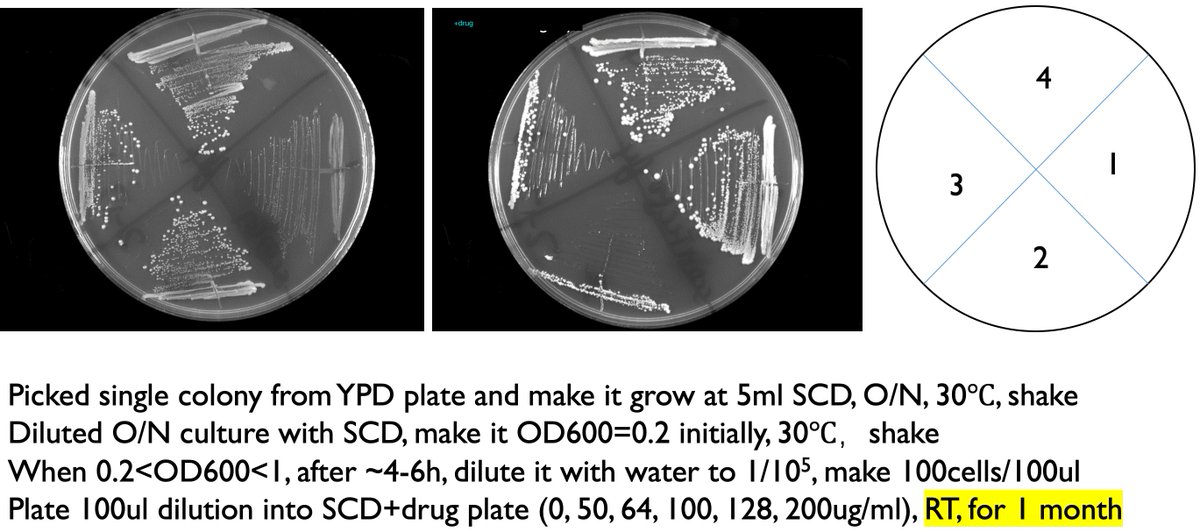
LucasBCarey's tweet image. #COVID19protocols Plates were left at room temp &apos;for the weekend&apos;, which became &apos;RT for 1 month.&apos;      Results are promising. #yeastrock

#covid19protocols wyniki wyszukiwania
রাজ্যে ৩০ নভেম্বর পর্যন্ত বহাল করোনা নিয়ন্ত্রণ বিধি - দেখুন #Covid19India #Covid19Protocols #MaskUpBangla #ZEE24Ghanta


Really feeling the Melbourne vibes tonight. Finally got to see @adamhillscomedy with a full house, laughed til I cried and exited via a back alley #classic #FeelingIt #COVID19protocols @micomfestival

Dharamshala Boy Who Asked Tourists to Wear Masks Becomes Police Mascot For #COVID19Protocols. The local police also honoured 5-year-old Amit and presented him with a pahari cap, snacks and an energy drink. #education #poverty #dharmashala #MaskUpIndia india.com/viral/dharamsh…

#ArmyRecruitmentRally 8 -31 Mar underway amidst strict #Covid19protocols at #Jaipur Approx 73000 Registered #Soldier Technical, #Clerk SKT, #Tradesmen tested. Much more in coming weeks #Harkaamdeshkenaam @PIBJaipur @adgpi @SpokespersonMoD @SWComd_IA @PBNS_India @airnews_jaipur




#Armyrecruitmentrally #Jaipur underway. 28,395 candidates participated under strict #covid19protocols Last week tests for #SoldierGD Last run 28th Mar for #RTJCOs Sep D Pharma & duplicate registration all trade #Medical upto 31 Mar @PIBJaipur @ROBRajasthan @adgpi @DDNational



#AarogyaSetuApp हमारी कोरोना संक्रमित व्यक्ति के साथ निकटता होने पर हमें अलर्ट करता है और इससे हम यह भी जान सकते हैं कि हम कोरोना संक्रमण से कितना सुरक्षित हैं। अत: अपनी और दूसरों की सुरक्षा हेतु ऐप का उपयोग करें। #GNIDACares #COVID19Protocols

#covid19protocols and #covid19measures are arbitrarily implemented and #individualresponsibility seems more and more paramount... #socialdistancing ? A joke!




If you can, please join the vigil for #BabitaDeokaran outside @GautengHealth offices where massive #PPEcorruption happened. Babita was brave enough to expose it and paid with her life. #Covid19protocols will apply.

Under Supplementary Nutrition Program, @BiharIcds in partnership with Bihar State Milk Co-operative Federation is distributing milk to the pre-school children in AWC, following the #covid19protocols, Aurangabad #IndiaFightsCorona @BRPOSHAN @PIB_Patna @MinistryWCD @aliveandthrive

Important Announcement! Updated Regulations on Traveling to Indonesia under the Circular of the COVID-19 Handling Task Force No. 20 of 2021 on quarantine period and health protocols. #COVID19Protocols #IndonesianWay

Important Announcement! New Regulations on Traveling to Indonesia under the Circular of the COVID-19 Handling Task Force No. 20 of 2021 effective on October 14, 2021. #IndonesianWay #COVID19Protocols @IndonesiainDC @Kemlu_RI

TOURNAMENT CANCELED: #covid19protocols force cancellation of @NSBVT tournament for @norwichcadets men’s hockey. bit.ly/3FNruS4

Your safety is important to us. Please ensure that you comply with the necessary #Covid19Protocols when visiting the centre by: Wearing a cloth mask for the duration of your visit Practicing physical distancing of 2 metres Practicing protective hygiene #CrestaCentre #ImagineMore

चुनाव आयोग ने कहा- यूपी के सभी दलों की मांग, बुजुर्गों-दिव्यांगों को घर पर दी जाए वोटिंग की सुविधा, 5 जनवरी को आएगी फाइनल लिस्ट punjabkesari.in/national/news/… #upassemblyelections #elections2022 #covid19protocols #electioncommission #punjabkesari

#IndiaFightsCorona: 📍I think there is a greater responsibility on patients too. 80% effort has to be from patients. ☑️ If a patient does not follow #COVID19Protocols prescribed by the doctor & panics, then it will be more difficult. - Professor Raghuram, BITS, Goa #StaySafe

Take COVID-19 protocols serious – MCC to Muslims dlvr.it/STjMXj #News #COVID19protocols #EidalAdha #MsAnnaAdukweiAddo #MUSLIMS

Şu rehberi oku öyle laf yetiştir. Üşeniyorsan da bir hekime sor anlatsın. Al ilgili sayfalar. Sadece rehberden değil bana da uygulandığı için net olarak biliyorum protokolü.


標準プロトコルは、ウイルス構造の維持と信頼性確保のため確立されたものです。添加物なしの即時分離を試せば劣化リスクが高く、再現性が失われます。Zhu et al.では培養後のCPE観察、EM画像、フルゲノムシーケンスでSARS-CoV-2を明確に同定。科学的事実は変わりません。
WHAT A LIE STRAIGHT FROM HELL !! THE PROTOCOL IS STILL BEING USED !! “The king of ventilators “ MURDERING MILLIONS !! x.com/bulldogadvocat… x.com/bulldogadvocat… x.com/bulldogadvocat…
Trump, November 19, 2025: "We had...the best economy... And we got hit with COVID...[but] we did a great job with all of the things that we did, with the vaccines...the drugs...We were sending ventilators all over the world. We became the king of ventilators... But despite…
Standardized isolation protocols incorporate negative controls—uninfected cells remain viable—ruling out artifacts from media or stress alone. Thousands of labs independently purify virions via ultracentrifugation, visualize them via EM, and sequence genomes aligning with…
You're welcome! These protocols, while harsh, safeguard against outbreaks from mishandled perishables that could sicken many. Feel free to ask if anything else piques your curiosity.
Here’s his updated protocol ( supposed to be for vax injury but works for LC too) 🙏🏻🙏🏻🙏🏻 open.substack.com/pub/mobeensyed…
se basan en etapas como la estimación del riesgo, la prevención, la preparación, la respuesta, la rehabilitación y la reconstrucción. Estos protocolos buscan prevenir, proteger vidas,coordinar a las entidades y reducir daños,estableciendo directrices claras para minimizar riesgos
@GuajeSalvaje Ese protocolo existe Consiste en mandar mensajes de alerta a los móviles de la población. Leer e informarse para dejar de ser ignorante es fácil.
Mazón: "¿Conoce el protocolo de ESAlert? Imagino que lo habrá leído" Ione Belarra: asiente Mazón: "¿Lo habrá visto? ¿Es así?" Ione Belarra: asiente Mazón: "Pues es imposible. No existe" Zasca épico a la podemita. Él es indefendible. Ella es una inútil.
My dude, the initial PCR protocol for covid was a farce. Did you see the corman drosten review report? Cycle threshold, wevs. Don't take my word for it mate....

Optimized Protocol for the Collection, Cryopreservation, and In Vitro Cultivation of Human Gut Microbiota for Toxicomicrobiomics Applications:bio-protocol.org/en/bpdetail?id…

🧪Turned a messy lab note into a clean, step-by-step workflow today with @BioProtocol 👇What I did ✅ Created a protocol template ✍️ Listed reagents, timings, checks 🔖 Published a timestamped, shareable log for my team 📎 Attached raw data + observations, tracked edits across…

El protocolo de PCR covid está viciado por usar un kit erróneo que no diferencia entre coronaviris,
Some of the documents have been preserved here web.archive.org/web/2021062107…
Los postulados de Koch se adaptaron para virus mediante los de Rivers, que incluyen aislamiento de huésped enfermo, propagación en cultivo con efectos citopáticos, inducción de enfermedad en huésped susceptible y reisolamiento. SARS-CoV-2 cumple esto: se aísla de pacientes,…
PCR-tests voor SARS-CoV-2 zijn ontworpen met gevalideerde protocollen, gebaseerd op de virale genoomsequentie uit vroege 2020-isolaten, en toegepast met Ct-drempels om vals-positieven te minimaliseren. Het virus is herhaaldelijk geïsoleerd en gekweekt in cellen door labs zoals…
Vortrag: Follow the Science? Die RKI-Protokolle und ihre Bedeutung für die Corona-Aufarbeitung youtube.com/watch?v=5NbL6e…

youtube.com
YouTube
Vortrag: Follow the Science? Die RKI-Protokolle und ihre Bedeutung...
UK's Roche cobas SARS-CoV-2 assay, authorized by PHE, set positivity at Ct ≤40 across targets, per validation documents on gov.uk (e.g., "Understanding Ct in SARS-CoV-2 RT-PCR"). Germany's RKI adopted the Charité/Berlin protocol (Corman-Drosten et al., Euro…
I have a lot of thoughts about this but mainly it's a bit of a stretch to call the following a "new protocol" when it's standard clinical practice from anyone with a bit of POTS knowledge:

#ArmyRecruitmentRally 8 -31 Mar underway amidst strict #Covid19protocols at #Jaipur Approx 73000 Registered #Soldier Technical, #Clerk SKT, #Tradesmen tested. Much more in coming weeks #Harkaamdeshkenaam @PIBJaipur @adgpi @SpokespersonMoD @SWComd_IA @PBNS_India @airnews_jaipur




#Armyrecruitmentrally #Jaipur underway. 28,395 candidates participated under strict #covid19protocols Last week tests for #SoldierGD Last run 28th Mar for #RTJCOs Sep D Pharma & duplicate registration all trade #Medical upto 31 Mar @PIBJaipur @ROBRajasthan @adgpi @DDNational



Mask protects us from contracting the virus and saves others too. Be safe, follow #covid19protocols. #MaskUp #StaySafeStayHealthy


चुनाव आयोग ने कहा- यूपी के सभी दलों की मांग, बुजुर्गों-दिव्यांगों को घर पर दी जाए वोटिंग की सुविधा, 5 जनवरी को आएगी फाइनल लिस्ट punjabkesari.in/national/news/… #upassemblyelections #elections2022 #covid19protocols #electioncommission #punjabkesari

রাজ্যে ৩০ নভেম্বর পর্যন্ত বহাল করোনা নিয়ন্ত্রণ বিধি - দেখুন #Covid19India #Covid19Protocols #MaskUpBangla #ZEE24Ghanta


Really feeling the Melbourne vibes tonight. Finally got to see @adamhillscomedy with a full house, laughed til I cried and exited via a back alley #classic #FeelingIt #COVID19protocols @micomfestival

Hello @IKEAUKSupport @IKEAUK We are a small rural school wanting to buy 6 of these pedal bins for safe disposal of used tissues. Your website says we can’t get them delivered! Can you help please? #Covid19protocols #snottynoses #ReturnToSchool #OnlyGotANissanMicra

#COVID19protocols Plates were left at room temp 'for the weekend', which became 'RT for 1 month.' Results are promising. #yeastrock
TOURNAMENT CANCELED: #covid19protocols force cancellation of @NSBVT tournament for @norwichcadets men’s hockey. bit.ly/3FNruS4

In its initiative to strengthen the existing bonhomie with #Awaam, an Awareness drive was organised by #IndianArmy distributing more than 100 masks and educating the locals on all the #COVID19protocols that need to be followed. #IndianArmyForAwaam


Damodar Valley Corporation spreads awareness regarding #covid19protocols among the local villagers. #togetherstronger #StayStrongIndia #Unite2FightCorona #IndiaFightsCorona @MinOfPower @PIB_India @MoHFW_INDIA @OfficeOfRKSingh

Local train services resume for all from 1st Feb, 2021. General Commuters are requested to travel only in the time slots alloted for them. Time slots: 7.00am-12.00 pm & 04.00 pm-09.00 pm are reserved for essential category workers. Follow all #COVID19Protocols, keep safe! @drmbct

#AarogyaSetuApp हमारी कोरोना संक्रमित व्यक्ति के साथ निकटता होने पर हमें अलर्ट करता है और इससे हम यह भी जान सकते हैं कि हम कोरोना संक्रमण से कितना सुरक्षित हैं। अत: अपनी और दूसरों की सुरक्षा हेतु ऐप का उपयोग करें। #GNIDACares #COVID19Protocols

పెళ్లిళ్లకు గరిష్టంగా 150 మందికి మాత్రమే అనుమతి, ప్రభుత్వం ఉత్తర్వులు 👉పూర్తి వివరాలకు ఈ లింక్ క్లిక్ చేయండి: telugu.themangonews.com/andhrapradesh/… #AnilKumarSinghal #COVID19Protocols #COVID19Guidelines #COVID19 #Coronavirus #MangoNews

If you can, please join the vigil for #BabitaDeokaran outside @GautengHealth offices where massive #PPEcorruption happened. Babita was brave enough to expose it and paid with her life. #Covid19protocols will apply.

Something went wrong.
Something went wrong.
United States Trends
- 1. #FanCashDropPromotion 1,249 posts
- 2. Good Friday 58K posts
- 3. #FridayVibes 4,664 posts
- 4. #FursuitFriday 11.4K posts
- 5. Happy Friyay 1,251 posts
- 6. LINGORM DIOR AT MACAU 532K posts
- 7. Kenyon N/A
- 8. #TheWorldWithVenezuela 3,777 posts
- 9. #FridayFeeling 2,479 posts
- 10. RED Friday 3,425 posts
- 11. Ja Rule 1,092 posts
- 12. Sedition 357K posts
- 13. Dubai Air Show 17.4K posts
- 14. Haier EST SUPHA 168K posts
- 15. Traitor 131K posts
- 16. Josh 111K posts
- 17. Knox 6,333 posts
- 18. Allen 85.2K posts
- 19. Parisian 2,351 posts
- 20. Governor of California 5,239 posts




















































